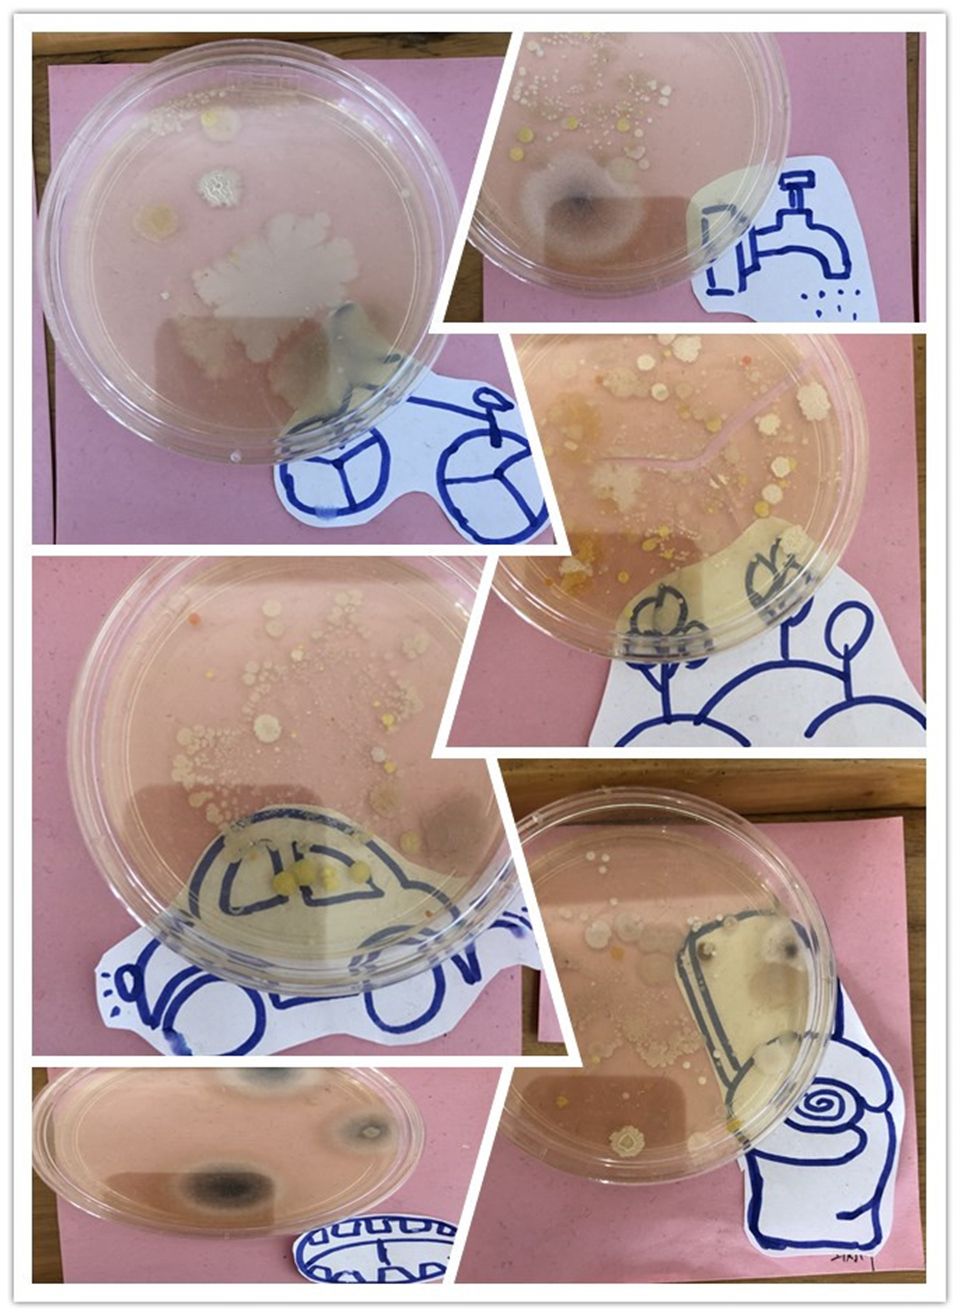
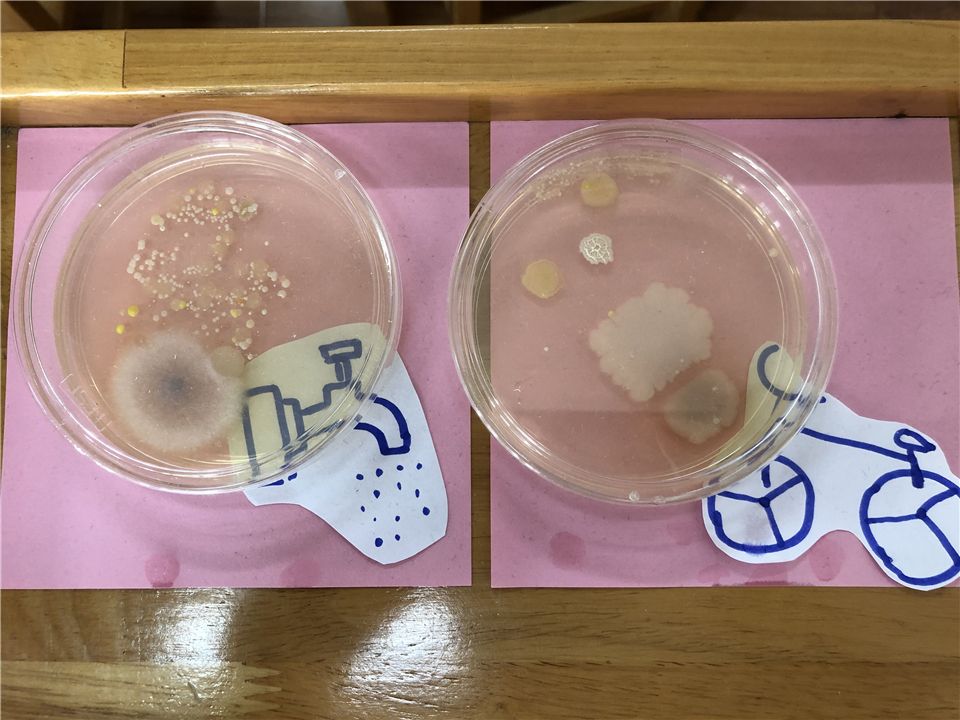
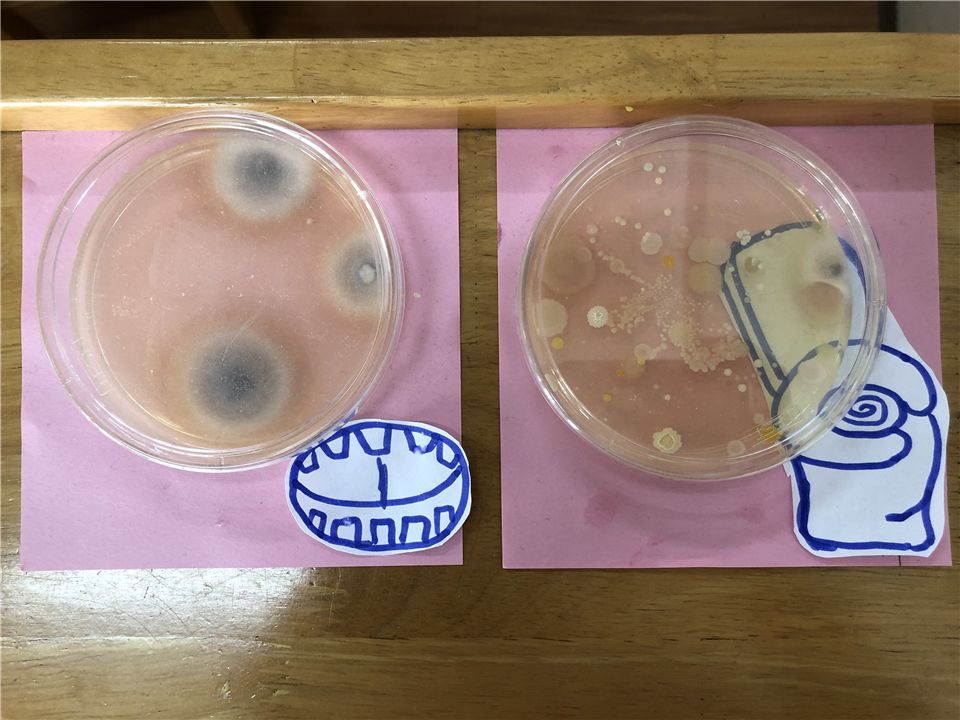
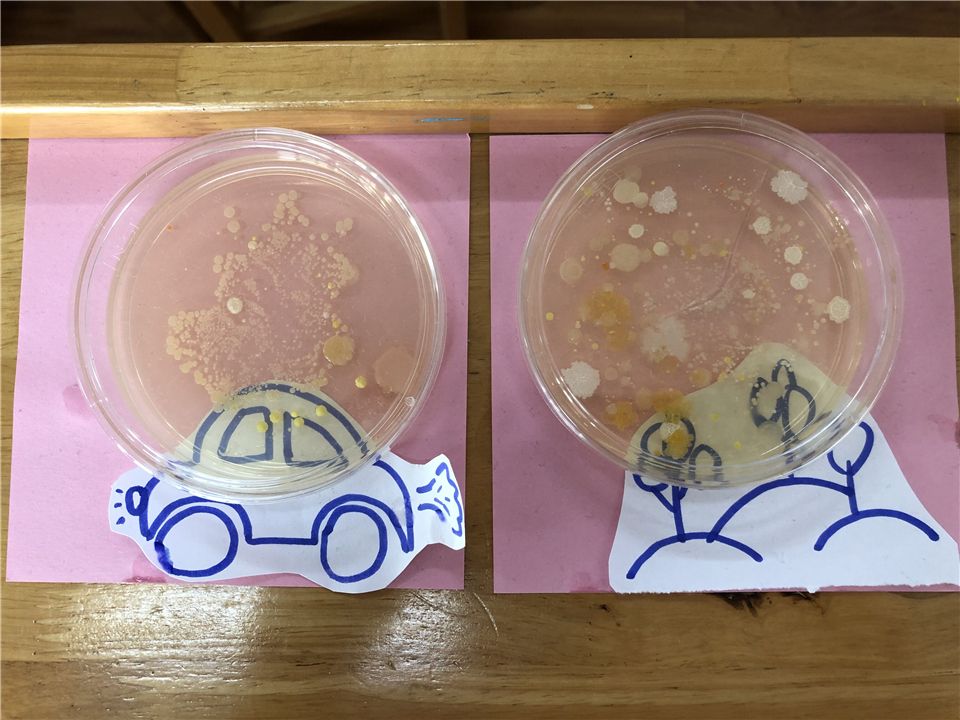

“细菌是圆的?扁的?方的?长角的?”萌娃们对“细菌”这个神秘的坏家伙很感兴趣,都想看看它到底长什么样子。在区域时间,萌娃们把想象中的“细菌”画了下来。




“为什么细菌会让我们生病呢?”
“有没有什么办法可以让我们看到细菌呢?”
“我爸爸可厉害了,在厦大实验室里面做实验,新冠病毒疫情的时候,他们都一直在做研究。”


为满足萌娃们的好奇心,我们联系了在厦大实验研究室工作的梓涵爸爸,他为大八班的萌娃们准备了一个秘密武器“营养琼脂培养基”,让萌娃们亲自做小实验。

让我们一起来找找身上的细菌吧!
萌娃们有早上坐汽车入园、坐自行车入园、不爱洗手的,还有口腔里的、上厕所的、去户外回来的,在老师的协助下,都将手上的细菌按在培养皿上,并做好标记!
好啦!接下来就等待细菌“成长”了。





培养皿出现了几个小白点...
培养皿开始开出“小花”...

...
培养皿上的细菌宝宝越来越多...
“哇!这个白白的东西就是细菌吗?”
“你看,我的细菌宝宝长出像小鸡身上的绒毛。”
“老师,快看,我的培养皿开花了。”
萌娃们叽叽喳喳的讨论着自己的发现,并把它记录下来!

通过对细菌的观察,萌娃们发现了细菌的不同形态,从而激发萌娃们养成良好的卫生习惯。
(林丽丽、黄诗韵)